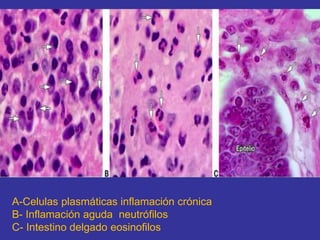
A-Celulas plasmáticas inflamación crónica
B- Inflamación aguda neutrófilos
C- Intestino delgado eosinofilos
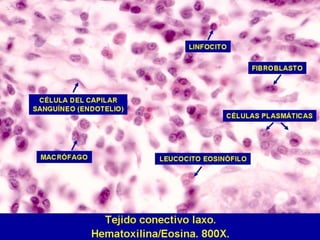

Este documento presenta información sobre el tejido conectivo. Explica que el tejido conectivo se compone de células separadas por una matriz extracelular. Luego describe los diferentes tipos de tejido conectivo, incluyendo el tejido conectivo propiamente dicho, el cartilaginoso y el óseo. Finalmente, detalla las diferentes células que componen el tejido conectivo, como fibroblastos, adipocitos, células plasmáticas y macrófagos.